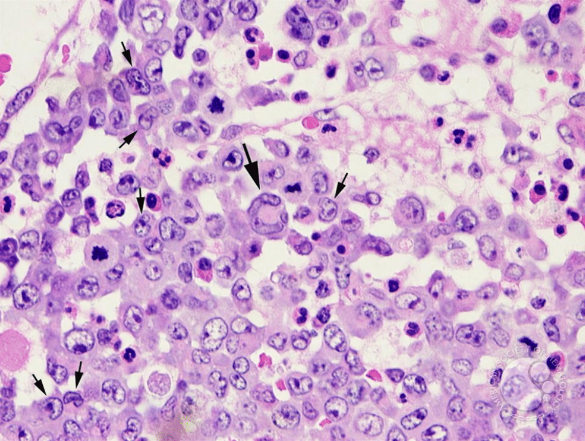

Presenter: Eric Sandrock, DO, Thomas L Davis, MD, Rick Lin, DO
Dermatology Program: South Texas Dermatology Residency, HCA Healthcare Corpus Christi Medical Center – Bay Area Program
Program Director: Rick Lin, DO MPH FAOCD
Submitted on: June 12, 2024
CHIEF COMPLAINT: “I have a painful bump growing on my foot”
CLINICAL HISTORY: A 40-year-old female with a medical history of anemia and hypothyroidism presented to our clinic with a two-month history of a rapidly growing, tender lesion on her right foot. The patient reported no prior trauma to the area and denied experiencing any similar lesions in the past. She also reported no discharge or itching at the site of the lesion. She reported no recent travel, exposure to sick contacts, and has no personal or family history of similar lesions or skin cancer.
During the evaluation, the patient denied additional systemic symptoms, including fever, chills, night sweats, or unintentional weight loss. Her surgical history was unremarkable, with no recent surgeries noted. The patient is currently on levothyroxine 125 mcg daily for her hypothyroidism.
PHYSICAL EXAM:
Physical examination demonstrated a solitary, tender nodule on the medial aspect of the right foot. Popliteal lymph nodes on the right lower extremity were slightly palpable but similar in comparison to the left side. There were no palpable inguinal lymph nodes.

LABORATORY TESTS: N/A
DERMATOHISTOPATHOLOGY:
Histopathologic examination revealed a centrally located ulceration adjacent to which the epidermis is markedly hyperplastic. The dermis demonstrated a dense and diffuse mixed infiltrate which extends to the base and peripheral edges of the specimen. The infiltrate contained numerous neutrophils and eosinophils as well as a large number of CD4+/CD30 enlarged lymphocytes with round, oval, and cleaved nuclei. Some were multinucleated and many had abundant cytoplasm. Mitotic figures were identified.
Approximately 60% of the small lymphocytes in the infiltrate were CD3+ T-cells and 40% CD20+ B-cells. The CD4:8 ratio was normal. Immunohistochemistry stains were negative for ALK-1 and EMA.
DIFFERENTIAL DIAGNOSIS:
1. Squamous Cell Carcinoma
2. Foreign Body
3. Sarcoma
4. Deep Fungal Infection
5. Poroma
6. Pyogenic Granuloma
7. Amelanotic Melanoma